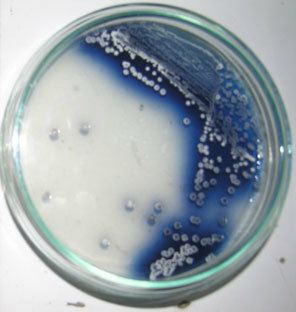
STREPTOMYCES COELICOLOR-Hopwood

-
Aunque el origen del microscopio es una cuestión aún incierta, se le considera a Zacharias Janssen como el inventor del microscopio compuesto (con dos lentes), tal vez con la ayuda de su padre.
-
 Francesco Redi fue el primero en refutar la teoría de la generación espontánea en gusanos.
Francesco Redi fue el primero en refutar la teoría de la generación espontánea en gusanos. -
 Anton van Leeuwenhoek es el primero en observar bacterias o "animálculos".
Anton van Leeuwenhoek es el primero en observar bacterias o "animálculos". -
Edward Jenner desarrolla la primera vacuna contra la viruela humana.
-
AGOSTINO BASSI Bassi demuestra que la muscardina era provocada por un cierto tipo de hongo que nombra Botrytis paradoxa (actual Beauveria bassiana, Vuillemin, 1912) .
-
 Miles Joseph Berkeley descubre un hongo (Phytophthora infestans) que produce la podredumbre de la patata.
Miles Joseph Berkeley descubre un hongo (Phytophthora infestans) que produce la podredumbre de la patata. -
PITIRIASIS VERSICOLOR En 1846, Eichstedt describió por primera vez el componente micótico de las lesiones de la pitiriasis versicolor.
-
Ignacio Felipe Semmelweis antisépticos para evitar la fiebre puerperal.
-
 John Snow realiza el primer estudio epidemiológico del cólera en Londres.
John Snow realiza el primer estudio epidemiológico del cólera en Londres. -
Louis Pasteur refuta de manera convincente la teoría de la generación espontánea.
-
 Robert Koch demuestra que el carbunco o ántrax es causado por Bacillus anthracis
Robert Koch demuestra que el carbunco o ántrax es causado por Bacillus anthracis -
JULIOS RICHARD PETRI Fue un microbiólogo alemán a quien se le atribuye la invención de la placa de Petri, mientras trabajaba como asistente de Robert Koch
-
 Carlos Finlay observa que la fiebre amarilla es transmitida por mosquitos.
Carlos Finlay observa que la fiebre amarilla es transmitida por mosquitos. -
 Robert Koch descubre el Mycobacterium tuberculosis.
Robert Koch descubre el Mycobacterium tuberculosis. -
El bacilo del cólera en 1883 y por el desarrollo de los postulados de Koch. Recibió el Premio Nobel de Medicina en 1905.
-
 Desarrollo de la tinción de Gram.
Desarrollo de la tinción de Gram. -
Louis Pasteur puso a punto una vacuna contra la rabia.
-
 Escherich descubre Escherichia coli.
Escherich descubre Escherichia coli. -
Richard Petri introduce el uso de las placas Petri en Microbiología.
-
Beijerinck aísla bacterias fijadoras de nitrógeno de los nódulos presentes en las raíces de leguminosas.
-
Serguéi Winogradski estudia las bacterias del azufre y las bacterias nitrificantes.
-
Dimitri Ivanovski demuestra que el mosaico del tabaco es producido por un virus.
-
 Fritz Schaudinn y Erich Hoffmann demuestran que el Treponema pálidum es el agente productor de la sífilis.
Fritz Schaudinn y Erich Hoffmann demuestran que el Treponema pálidum es el agente productor de la sífilis. -
Walter Reed confirma que la fiebre amarilla es transmitida por mosquitos, hecho previamente observado por Carlos Finlay en 1881.
-
Howard Taylor Ricketts demuestra que la fiebre de las Montañas Rocosas es transmitida por garrapatas, y aisló el microorganismo causante de la enfermedad (que él llamó rickettsia). Falleció por esa enfermedad.
-
 Paul Ehrlich descubre el salvarsán (balas mágicas), primer agente quimioterapéutico contra la sífilis.
Paul Ehrlich descubre el salvarsán (balas mágicas), primer agente quimioterapéutico contra la sífilis. -
Francis Peyton Rous descubre el virus (retrovirus) que produce tumores (sarcomas) en pollos.
-
 Frederick Twort descubre los virus que infectan bacterias (bacteriófagos).
Frederick Twort descubre los virus que infectan bacterias (bacteriófagos). -
 Félix d'Herelle descubre más virus bacteriófagos.
Félix d'Herelle descubre más virus bacteriófagos. -
 Se publica por primera vez el Manual Bergey de Microbiología.
Se publica por primera vez el Manual Bergey de Microbiología. -
 Frederick Griffith lleva a cabo el descubrimiento de la transformación bacteriana.
Frederick Griffith lleva a cabo el descubrimiento de la transformación bacteriana. -
 Alexander Fleming aísla la penicilina de un cultivo de Penicillium notatum.
Alexander Fleming aísla la penicilina de un cultivo de Penicillium notatum. -
Frits Zernike desarrolla el microscopio de contraste de fases que permite ver microorganismos vivos.
-
 Helmut Ruska inventa el microscopio electrónico.
Helmut Ruska inventa el microscopio electrónico. -
Wendell Meredith Stanley consigue cristalizar el virus del mosaico del tabaco (que permaneció activo después de la cristalización).
-
Domagk descubre las sulfamidas, el primer agente quimioterapéutico.
-
Albert Schatz aísla la estreptomicina de un cultivo de Streptomyces griseus. Su jefe, Selman Waksman, se apodera del descubrimiento y gana el premio Nobel de Medicina de 1952.
-
Joshua Lederberg y Edward Lawrie Tatum demuestran la existencia de conjugación en Escherichia coli.
-
 André Michel Lwoff estudia el fenómeno de la lisogenia.
André Michel Lwoff estudia el fenómeno de la lisogenia. -
 Alfred Hershey y Martha Chase demuestran que el DNA era el material genético de algunos virus.
Alfred Hershey y Martha Chase demuestran que el DNA era el material genético de algunos virus. -
Norton Zinder y Joshua Lederberg descubren el fenómeno de la transducción generalizada.
-
 Joshua Lederberg introduce el concepto de plásmido.
Joshua Lederberg introduce el concepto de plásmido. -
James D. Watson y Francis Crick consiguen dilucidar la estructura en doble hélice del DNA.
-
François Jacob y Wollman demuestran la existencia del plásmido F en Escherichia coli.
-
François Jacob y Jacques Monod proporcionan el primer ejemplo de control de la expresión de genes a nivel de transcripción: modelo del operón.
-
 Marshall Nirenberg y Matthaei descubren que el codón UUU codificaba para el aminoácido fenilalanina, experimento que sentó las bases para la elucidación del código genético.
Marshall Nirenberg y Matthaei descubren que el codón UUU codificaba para el aminoácido fenilalanina, experimento que sentó las bases para la elucidación del código genético. -
 Robert W. Holley aísla los tRNA, moléculas que incorporan los aminoácidos activados en las proteínas.
Robert W. Holley aísla los tRNA, moléculas que incorporan los aminoácidos activados en las proteínas. -
Werner Arber, Daniel Nathans y Hamilton Smith descubren los enzimas de restricción, herramientas esenciales para el desarrollo de la Ingeniería Genética.
-
 Bruce Ames pone a punto un test bacteriano para detectar mutágenos y carcinógenos: el test de Ames.
Bruce Ames pone a punto un test bacteriano para detectar mutágenos y carcinógenos: el test de Ames. -
 Frederick Sanger desarrolla el método de los dideoxinucleótidos para la secuenciación del DNA.
Frederick Sanger desarrolla el método de los dideoxinucleótidos para la secuenciación del DNA. -
 Woese y George E. Fox reconocen las archeas como el tercer dominio de los seres vivos.
Woese y George E. Fox reconocen las archeas como el tercer dominio de los seres vivos. -
 Maxam y Walter Gilbert ponen a punto un método químico para la secuenciación del DNA.
Maxam y Walter Gilbert ponen a punto un método químico para la secuenciación del DNA. -
 Robert Gallo y Luc Montagnier llevan a cabo el aislamiento e identificación del virus del sida.
Robert Gallo y Luc Montagnier llevan a cabo el aislamiento e identificación del virus del sida. -
Kerry Mullis utilizó la Taq polimerasa para llevar a cabo la PCR (reacción en cadena de la polimerasa).
-
Barry Marshall y Robin Warren demuestran el papel de Helicobacter pylori en la úlcera de estómago.
-
 Clements y Bullivant descubren Epulopiscium fishelsoni, la mayor célula procariota.
Clements y Bullivant descubren Epulopiscium fishelsoni, la mayor célula procariota. -
 Se secuencia el genoma de la bacteria Haemophilus influenzae.
Se secuencia el genoma de la bacteria Haemophilus influenzae. -
Se secuencia el genoma de la bacteria Saccharomyces cerevisiae.
-
Se secuencia el genoma de la bacteria Escherichia coli.
-
Heidelberg y col. descubren que Vibrio cholerae tiene dos cromosomas circulares.
-
Hopwood y col. realizaron la secuenciación del genoma de Streptomyces coelicolor.
Hopwood y col. realizaron la secuenciación del genoma de Streptomyces coelicolor. -
 Aparece en Asia la gripe aviar, producida por el subtipo H5N1 del virus Influenza A que puede transmitirse al hombre.
Aparece en Asia la gripe aviar, producida por el subtipo H5N1 del virus Influenza A que puede transmitirse al hombre. -
Secuenciación del genoma de Legionella pneumophila, el microorganismo productor de la enfermedad de los legionarios.
-
Deinococcus radiodurans, el primer microorganismo descubierto que posee entre 4 y 12 copias adicionales de su genoma, cualquiera de las cuales puede usarse en caso de sufrir el efecto de dosis elevadas de radiaciones.
-
Se secuencia el genoma del Saccharopolyspora erythraea, el microorganismo productor del antibiótico eritromicina.
-
 En México aparece un brote de gripe porcina, posteriormente llamada gripe A H1N1.
En México aparece un brote de gripe porcina, posteriormente llamada gripe A H1N1. -
Se descubre el proceso de esporulación en Mycobacterium.
-
Bacillus subtilis puede producir dos esporas en la misma célula madre.
-
Caracterización "in vivo" e "in vitro" del virus H1N1.
-
 Incorporación de bacterias en viajes interplanetarios.
Incorporación de bacterias en viajes interplanetarios. -
 Grandes avances en terapia génica
Grandes avances en terapia génica -
 La OMS publica su primera validación para uso en emergencias de una vacuna contra la COVID-19 y hace hincapié en la necesidad de un acceso mundial equitativo
La OMS publica su primera validación para uso en emergencias de una vacuna contra la COVID-19 y hace hincapié en la necesidad de un acceso mundial equitativo
Looking for a timeline maker?
Create timelines for projects, roadmaps, history, lessons, legal cases, and stories with Timetoast. Timetoast is a timeline maker for work, school, research, and stories.



































